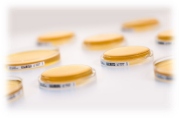

Naughton Penn Consultants (NPC) has shared an insight into its wide-range of products on display.
With a strong focus on environmental monitoring NPC has products and services that can assist you in getting reliable and repeatable results with a significant reduction in non-conformances, time, and cost.
Our culture media is coming from PMM. A German company that has a reputation for supplying media of the very highest quality. They are the only company that manufactures solely for pharmaceutical customers, they produce their media in Grade A facilities ensuring contamination free.

All PMM media is manufactured with a minimum of 12 months shelf life and can be stored at ambient temperature. The media is supplied with a minimum fill of 30ml in locking petri dishes as a standard feature. All PMM products have a unique bar code and come supplied in totally impermeable packaging. Discuss with NPC how our media products can significantly reduce your non-conformances and costs of doing the Growth promotion Tests.
Accompanying the PMM media we have control strains with a difference. Ielab control strains are produced from the CECT collection of Spain and conform with all regulations for the use of standardised microbial strains. They come supplied in a unique cartridge style packaging designed to reduce handling as much as possible.
Ielab control strains do not require any special dilution fluids, thereby reducing the cost of shipping fluids and unnecessary validation work. The control strains deliver exactly the concentrations that you require and can be tailormade to your own specifications.

To conform with the latest data integrity regulations and the Annex1 requirements we have SherpaPharma environmental monitoring software. An EM software designed with the Microbiologist in mind. SherpaPharma has been designed by those that have worked in the sterile pharmaceutical industry. This software operates in the cloud, is extremely simple to install and use whilst encompassing all that is required for data handling, it will enable you to conform to the latest regulations. SherpaPharma software will enable you to perform fast data analysis and can produce reports instantly from thousands of results.
We look forward to discussing how we can assist you with your environmental monitoring.
Visit our stand at Cleanroom Technology Birmingham May 24th & 25th Stand E6.
www.naughtonpenn.com
